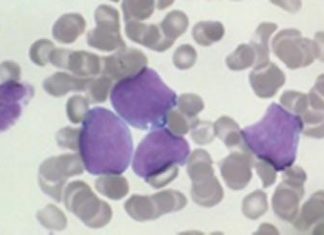
Researchers discover a fundamental feature of aggressive lymphomas Researchers discover a fundamental feature of aggressive lymphomas

Study: Eating peanuts may lower risk of ischemic stroke, cardiovascular disease...
Asian men and women living in Japan who ate peanuts (on average 4-5 peanuts/day) had a lower risk of having an ischemic stroke or...
Surroundings affect rhythm of an individual’s walk, says study
Scientists at the University of Bristol have discovered that people who felt more at ease in urban environments had as regular stepping patterns as...
Study: Phase 2 Trial of MT-3921 initiated for treatment of spinal...
Mitsubishi Tanabe Pharma Corporation (MTPC, Head Office: Chuo-ku, Osaka; President & Representative Director, CEO: Hiroaki Ueno) and Professor Toshihide Yamashita at the Department of...
First global research of wildfire pollution reveals increase in mortality rate
The first study into the global impact of wildfire-related pollution and deaths comprehensively links short term exposure to wildfire-related fine particulate matters (PM2.5) in...
Walgreens COVID Vaccine registration and Online Scheduling: How to get appointments
Individuals 12 years old or older who reside in New York State are eligible to receive a vaccine for free.
Which states will offer Walgreens...
Avocados change belly fat distribution in women, says study
An avocado a day could help redistribute belly fat in women toward a healthier profile, according to a new study from the University of...
Only one in five sick older patients has formal ‘do not...
Only around 1 in 5 very sick older patients has a ‘do not resuscitate’ decision recorded at the time of their emergency admission to...
Research shows fact checks significantly reduce belief in misinformation
Fact-checking reduces belief in misinformation and leaves a more enduring mental imprint than false claims, according to a new study published today in the...
Electronic nose can sniff out when a lung transplant is failing...
An electronic “nose” is capable of detecting with 86% accuracy when a lung transplant is beginning to fail, according to research presented at the...
Researchers discover a fundamental feature of aggressive lymphomas
Research led by the University of Southampton has revealed a new fundamental feature of aggressive B-cell lymphomas which could open the door to further...